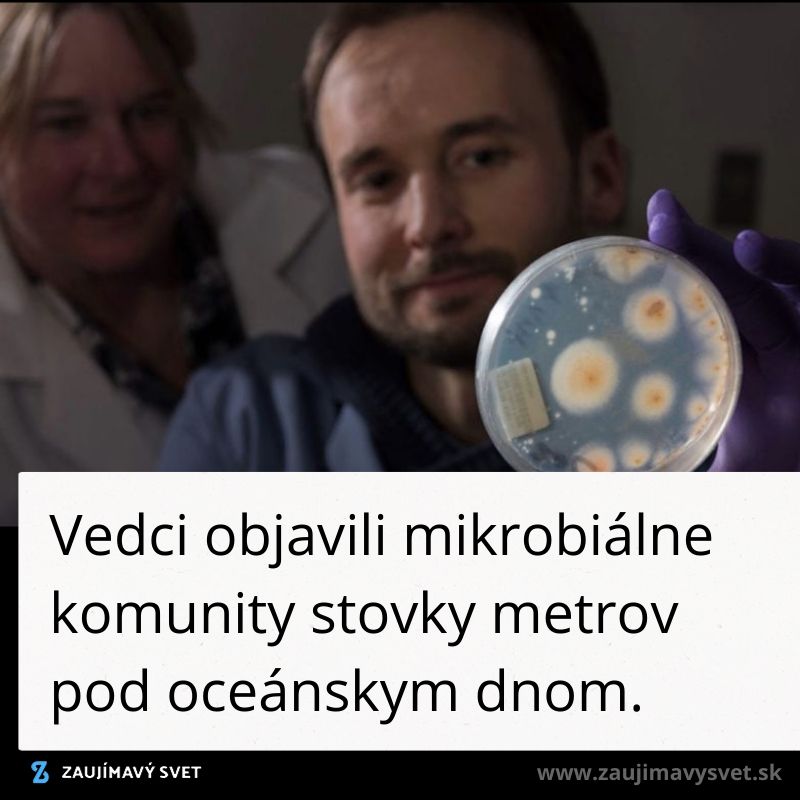

Prinášame vám najaktuálnejšie správy, zaujímavosti a informácie, ktoré vám poskytnú prehľad o dianí vo svete. Dnes sa dozviete o tom ako dlho zostáva koronavírus na rôznych povrchoch, o tom ako nezodpovedne k pandémii pristupuje grécka ortodoxná cirkev, alebo o objavenom živote stovky metrov pod oceánskym dnom.
Výskum prebiehal v laboratórii, kde sú všetky podmienky stabilné, vo svete teda môžu tieto časy ovplyvniť faktory ako slnečné svetlo a podobne. Podľa testov sa správa vírus veľmi podobne ako SARS v roku 2003. Vedci, ktorí sa podieľali na tejto štúdii upozorňujú, že umývanie rúk je najlepšia ochrana.
Doteraz si mysleli ľudia, že korytnačky považovali plasty za medúzy. Výskum ale ukázal, že korytnačky priťahuje ku plastom zápach. Zápach vytvárajú oceánske organizmy, ktoré sa prichytávajú na plast. Tieto zistenia môžu byť veľmi prospešné pre zníženie negatívnych dôsledkov plastu v oceáne. Skupina vedcov momentálne hľadá ďalšie dôkazy aby podporili teóriu.
Skalné jadrá, ktoré vyvŕtali z oceánskeho pohoria ukázali, že v podmorskej kôre žijú baktérie, huby a rôzne jednobunkovce. Čo sa týka života na zemi sú tieto miesta jednými z posledných nepreskúmaných oblastí na zemi.
V prípade, že ste zmeškali predchádzajúcu časť, môžete to napraviť na tomto odkaze.